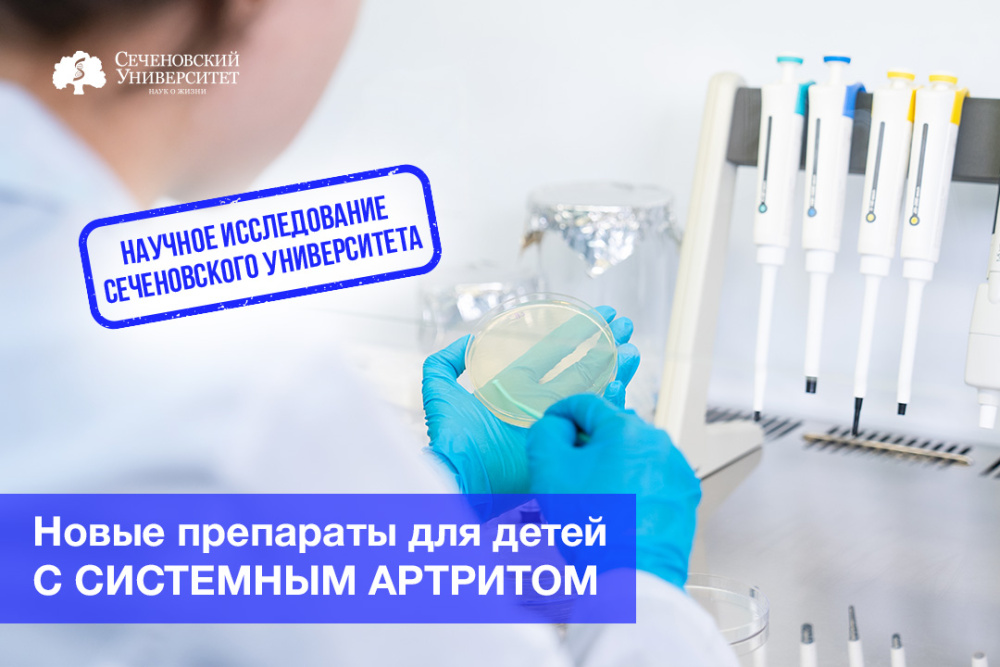
В Сеченовском Университете испытают новые препараты для детей с системным артритом
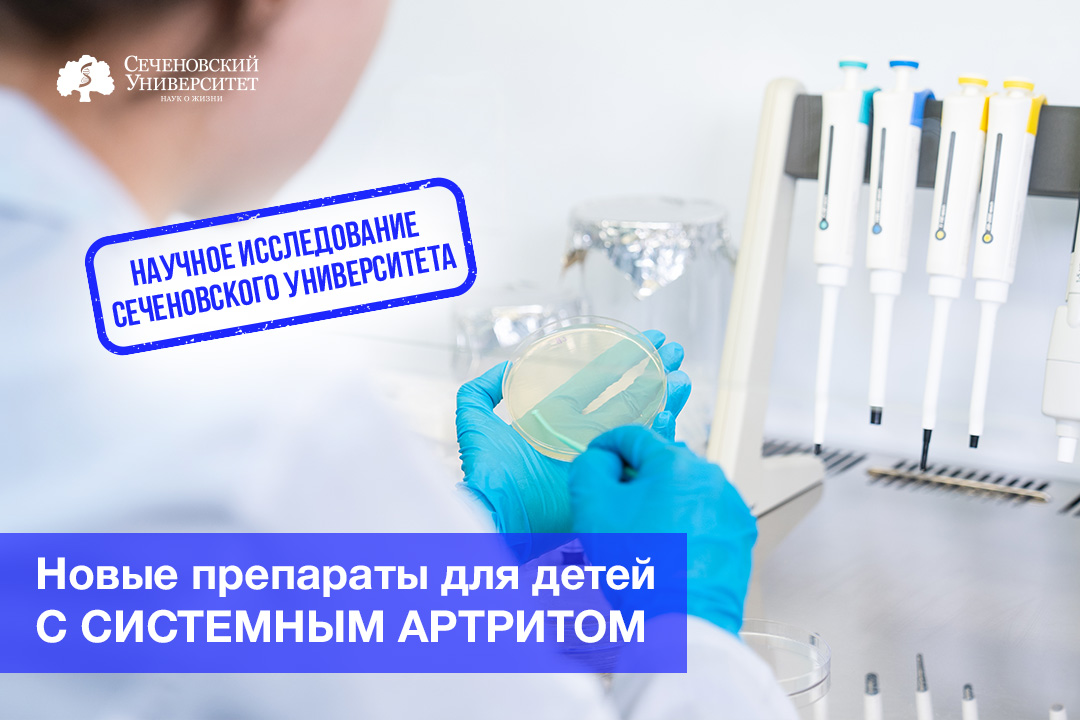
В Сеченовском Университете испытают новые препараты для детей с системным артритом

В Сеченовском Университете испытают новые препараты для детей с системным артритом
Инновационные лекарства помогают прекратить агрессию иммунной системы против собственного организма и предотвратить инвалидность
В России ювенильным артритом болеют 20 тысяч детей. Если заболевание не лечить, оно может разрушить суставы, привести к слепоте и поразить практически все органы. В то же время препаратов, подходящих для терапии самого тяжелого варианта ювенильного артрита – системного, – меньше, чем для лечения остальных. В Сеченовском Университете проведут клинические исследования двух новых генно-инженерных препаратов для борьбы с этим заболеванием. Об этом в преддверии Дня распространения информации о ревматоидном артрите, который отмечают 2 февраля, рассказала директор Клинического института детского здоровья имени Н. Ф. Филатова Сеченовского Университета, заведующая кафедрой педиатрии и детской ревматологии Первого МГМУ, заведующая ревматологическим отделением Национального медицинского исследовательского центра здоровья детей Минздрава России, главный внештатный детский специалист ревматолог Минздрава России, член-корреспондент РАН Екатерина Алексеева.
– Екатерина Иосифовна, что меняется в лечении ювенильного артрита?
– В целом лечение направлено на то, чтобы прекратить боевые действия иммунной системы против своего собственного организма. Ювенильный артрит – это генетически детерминированное заболевание, то есть у пациентов есть поломки в генах, регулирующих работу иммунной системы. В итоге она распознает клетки организма как врагов.
Болеют дети всех возрастов. Сейчас наблюдаем «омоложение» заболевания. В Сеченовском центре материнства и детства мы все чаще принимаем малышей, которые заболели на первом, втором году жизни. Всего у детей бывает семь вариантов ювенильного артрита. Чаще всего артрит поражает суставы – возникает припухлость, боль, утренняя скованность. Если затронуто большое количество суставов, ребенок может потерять способность двигаться. Есть вариант артрита, который поражает сосудистую оболочку глаза, что может привести к снижению остроты зрения и слепоте. Он называется увеит. Некоторые виды могут привести к цитокиновому шторму, когда огромное количество провоспалительных белков оказывает токсический эффект практически на все органы и ткани, что угрожает жизни.
Еще буквально пару десятков лет назад в таких случаях большинство детей было обречено на инвалидность – болезнь разрушала их суставы и другие органы. Чтобы понять, о чем идет речь, можно посмотреть на поздние портреты Огюста Ренуара – его руки были искорежены ревматоидным артритом, и когда он писал свои последние картины, кисть приходилось привязывать, так как пальцы уже не работали. А остановить болезнь было крайне сложно не только в XIX, но и в XX веке.
Когда около 25 лет назад я пришла работать в Клинику детских болезней после окончания лечебного факультета Первого МГМУ, у нас в арсенале были только метотрексат – препарат, который подавляет гиперактивность иммунной системы, – и инъекции кортикостероидных гормонов в суставы. Это было эффективно далеко не всегда. Особенно сложно было бороться с системным артритом – самым тяжелым видом заболевания. Нередко у пациентов развивался вторичный амилоидоз. Это тяжелое осложнение, при котором из-за воспалительной активности патогенный белок-амилоид накапливается в почках, печени, кишечнике, мозге, сердце, постепенно вытесняет нормальные клетки, в результате чего развивается полиорганная недостаточность и человек погибает. Болезнь можно было подавить только очень высокими дозами кортикостероидов, что, в свою очередь, тоже приводило к осложнениям. В том числе к задержке роста – подростку могло быть уже 15-16 лет, а рост у него оставался 105 сантиметров.
В начале 2000-х в ревматологии произошла революция – в России началась эра таргетной терапии. Ученые выявили, можно сказать, виновников происходящего в организме детей и взрослых с ювенильным и ревматоидным артритом. Ими оказались цитокины – провоспалительные белки, которые отвечают за избыточную активность иммунной системы. И против них были синтезированы препараты, которые воздействуют именно на эти белки.
В 2002 году мы в Клинике детских болезней Сеченовского Университета впервые применили инновационный генно-инженерный биологический препарат – инфликсимаб. Это было невероятно. Помню, мама пациента сидела в коридоре и плакала – ее ребенок не мог встать, лежал весь опухший, глаза слезились, на свет он вообще не мог смотреть, так как были поражены и суставы, и глаза. А на следующее утро после введения препарата он смог встать с кровати, и у него не было даже скованности в движениях. Сейчас больные, которых мы лечили первыми генно-инженерными препаратами, уже взрослые. Некоторые из них учатся на педиатрическом факультете Сеченовского Университета.
С тех пор был создан ряд препаратов, которые воздействуют на различные мишени, так как у каждого вида ювенильного артрита свой механизм развития. Клинический институт детского здоровья имени Н. Ф. Филатова и Сеченовский центр материнства и детства участвуют в клинических исследованиях новых препаратов.
– Какие исследования идут сейчас и начнутся в ближайшее время?
– Сейчас идет исследование нового препарата – олокизумаба. Это не аналог какого-то существующего препарата, а совершенно новая молекула – моноклональное антитело к провоспалительному интерлейкину-6. Препарат производит отечественная фармкомпания «Р-Фарм». У нас уже закончился первый этап исследования среди детей с преимущественно суставным поражением. У них олокизумаб показал высокую эффективность и безопасность. А теперь мы начнем исследование у детей с юношеским артритом с системным началом – самой редкой и наиболее тяжелой формой заболевания, которое сопровождается температурой, цитокиновым штормом и бешеной воспалительной активностью, опасной для жизни. А интерлейкин-6 – это как раз центральный цитокин, участвующий в развитии этого варианта заболевания, так что воздействовать нужно именно на него. Это будет прорывом, так как сейчас в арсенале ревматологов только два препарата для лечения системного юношеского артрита, тогда как для лечения других вариантов – почти десять препаратов.
Сеченовский Университет также станет одним из центров, который будет по протоколу, подготовленному экспертным врачебным сообществом, участвовать в клиническом испытании отечественного биоаналога уже существующего зарубежного препарата – моноклонального антитела к рецептору интерлейкина-6. Он называется «Компларейт», его производит компания АО «Генериум». Надо сказать, что это первый случай, когда проводят клиническое испытание биоаналога среди детей. Это очень важно для того, чтобы оценить его эффективность и безопасность для детей с юношеским артритом с системным началом. К испытаниям мы приступим в марте.
– Если артрит генетически детерминирован, можно ли определить склонность к заболеванию с помощью генетического теста?
– К сожалению, нет. Работа иммунной системы регулируется генетикой – иммунитет реагирует на чужеродные антигены, например на инфекции. Но артрит – полигенное заболевание, то есть у нас нет определенного гена-кандидата, про который мы могли бы сказать: если мы наблюдаем определенный вариант этого гена, это приведет к развитию ювенильного артрита.
– А как тогда диагностировать заболевание на ранних стадиях?
– Многое зависит от внимательности врачей. Есть варианты артрита, которые очень сложно распознать. В том числе это юношеский артрит с системным началом. Часто он начинается с высокой температуры и сыпи, и ребенка начинают лечить от респираторной инфекции. Анализ крови тоже не помогает – ее показатели характерны и для инфекционного заболевания. Но есть отличительная черта – у ребенка начинают болеть суставы. В этом случае внимательный врач пригласит ревматолога, чтобы провести обследование по протоколу установления диагноза «ювенильный артрит».
Прежде чем поставить диагноз, нужно исключить все «маски», потому что проявления артрита могут быть сходны с симптомами не только инфекций, но и онкологических заболеваний, травм и так далее. И сделать это необходимо до назначения глюкокортикоидных гормонов, которые снимают температуру, сыпь и воспаление. Иначе можно пропустить проявления артрита или онкологии – человек почувствует себя совершенно здоровым, но как только действие препаратов закончится, симптомы вернутся.
Часто ювенильный артрит стартует после перенесенного инфекционного заболевания. Например, ребенок переболел респираторной или кишечной инфекцией, а через 1−2 недели после этого у него опух сустав. В этом случае лучше проконсультироваться с ревматологом. Иногда заболевание дебютирует после травмы, когда ребенок, скажем, упал и ударился коленом. Естественно, родители ведут его к травматологу. А это может быть не перелом или надрыв связки, а поражение сустава.
Бывает, что проблем с суставами еще нет, но уже поражается сосудистая оболочка глаза. А родители обращают на это внимание, только когда ребенок начинает плохо видеть, натыкаться на предметы. В этом случае ребенок может попасть к ревматологу гораздо позже, чем хотелось бы.
– Вы сказали, что ювенильный артрит стартует после инфекционных заболеваний. А есть ли какая-то связь с COVID-19?
– Различные исследования показали, что после ковида нередко стартуют аутоиммунные заболевания, потому что белковые молекулы SARS-CoV-2 похожи на белковые молекулы человека, и иммунная система может «путаться» между «своими» и «чужими» белками. Мы провели свое исследование и выяснили, что у детей, у которых ревматические заболевания дебютировали после коронавируса, такие заболевания часто протекали тяжелее, не отвечали на стандартную терапию и нередко сопровождались цитокиновым штормом. Причем COVID-19 мог протекать и бессимптомно. То, что ребенок переболел, выяснялось позже, когда обнаруживалось аутоиммунное заболевание.
Поэтому я убежденный сторонник вакцинации детей от ковида. Зарегистрированы две вакцины для детей 12−16 лет и 6−12 лет. Сеченовский центр материнства и детства участвовал в их клинических испытаниях, и результаты были очень хорошие – вакцины безопасны и эффективно защищают детей. Лучше вакцинироваться, чем ждать, какие последствия могут возникнуть.
Второй момент – примерно у половины детей, у которых уже есть ревматические заболевания, включая ювенильный артрит, дерматомиозит и волчанку, после ковида происходило обострение заболевания, даже если они находились в глубокой ремиссии. Но вакцинировать их мы не могли, чтобы не получить обострение ревматических заболеваний. Поэтому мы начали применять препарат для профилактики ковида, который вакциной не является. Он состоит из двух моноклональных антител к вирусу SARS-CoV-2 –«тиксагевимаб + цилгавимаб». По сути, это готовый иммуноглобулин, который при попадании вируса в организм начинает с ним бороться. Ведь у детей, которые получают иммунодепрессанты, антитела к SARS-CoV-2 могут не выработаться или их будет слишком мало. Мы применили антитела у 300 детей и получили потрясающий ответ: ковидом заболели только шесть детей, а побочные эффекты мы не зафиксировали. Эффект сохранялся 6–9 месяцев. Сейчас отечественные фармкомпании работают над аналогичными препаратами для новых штаммов коронавируса.